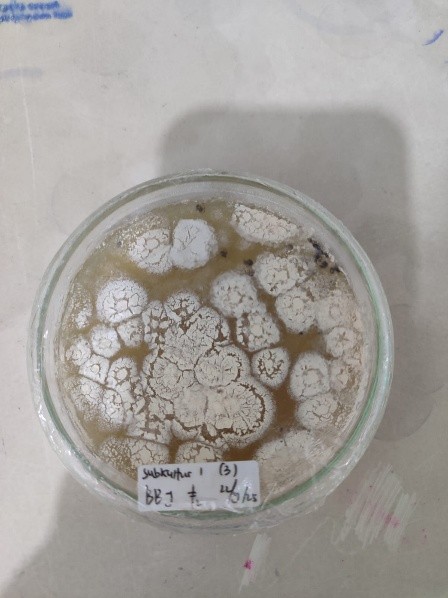
Gambar (a) Isolat Beauveria bassiana

Perbanyakan Agen Pengendali Hayati (Beauveria basiana) di UPTD PKDLHP
Pengendalian hayati (biological control) merupakan cara pengendalian penyakit yang melibatkan musuh alami yang menguntungkan untuk mengurangi atau mengendalikan hama penyakit tanpa merusak lingkungan. Keuntungan dari pengendalian hayati meliputi ramah lingkungan, berkelanjutan, target spesifik dan mengurangi resistensi hama. Pengendalian hayati ini dapat menggunakan jamur entomopatogenik dan jamur antagonis seperti Beauveria bassiana dalam menggendalikan hama Helopeltis.
Beauveria basiana merupakan salah satu jamur entomopatogen termasuk organisme heterotrof yang bersifat parasit bagi serangga inang. Serangga yang terinfeksi B. bassiana akan mengeras dan mengeluarkan miselium berwarna putih. Proses B. bassiana dalam menginfeksi inang terdiri dari beberapa tahap, yakni penempelan konidia pada tubuh serangga, perkecambahan konidia, penetrasi dan invasi, serta pemusnahan. Berikut contoh gambar serangga Helopeltis yang terserang B. basiana.

Dalam dunia pertanian Beauveria bassiana memiliki kebermaanfaatan yang baik sehingga perlu untuk dikembangkan.
UPTD Perbenihan Kebun Dinas dan Laboratorium Hayati Perkebunan dibawah Dinas Pertanian dan Ketahanan Pangan Provinsi NTT telah melakukan perbanyakan berbagai Agen Pengendali Hayati (APH) diantaranya Beauveria bassiana. Proses perbanyakan APH ini rutin dilakukan oleh Seksi Pengelolaan Laboratorium dan Biopestisida melalui beberapa tahap yaitu:
1. Isolat Beauveria bassiana
- Membuat media agar sebagai media tumbuh islolat Beuveria bassiana
- Melakukan isolasi atau pemurnian islolat Beuveria bassiana
- Melakukan identifikasi dan pengamatan pertumbuhan isolat ± 5-7 hari

2. Starter Beauveria bassiana
- Membuat media tumbuh dari beras yang telah dikukus setengah matang kemudian ditaburi gula pasir 1- 2 sendok
- Menimbang media beras sebanyak 50gram dalam plastik bening tahan panas yang kemudian disterilisasi menggunakan autoclave pada suhu 121°C selama 20–30 menit
- Setelah media beras dingin dilanjutkan dengan inokulasi isolat Beauveria bassiana pada media beras secara aseptis untuk dijadikan starter
- Melakukan identifikasi dan pengamatan rutin pertumbuhan starter Beauveria bassiana
Setelah 7 – 10 hari Starter B. Bassiana dapat diaplikasikan pada tanaman. Pengaplikasiannya dapat dilakukan dengan cara dicampur langsung ke tanah pembibitan atau dilarutkan dalam air + larutan gula untuk aplikasi siram. Perbandingan larutan dapat menggunakan 1 gelas air mineral larutan untuk 1 tangki semprot 14 liter. Aplikasikan ke tanaman pada sore hari, seminggu sekali.



